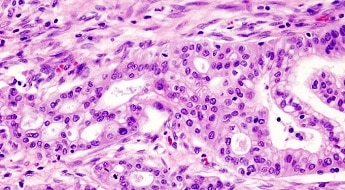

L’étude clinique franco-canadienne PRODIGE 24/CCTG PA.6 conduite par Unicancer et le Groupe canadien des essais sur le cancer (CCTG) auprès de 500 patients opérés d’un adénocarcinome canalaire du pancréas (forme la plus fréquente de cancer du pancréas) montre une augmentation significative de la survie chez les patients traités par le protocole de chimiothérapie mFOLFIRINOX en comparaison du traitement standard par gemcitabine. Cette étude internationale coordonnée par le Pr Thierry Conroy (Institut de cancérologie de Lorraine, Nancy), ainsi que le Pr Jean-Baptiste Bachet (Hôpital La Pitié-Salpêtrière, AP-HP, Paris) et le Pr Patrick Rat (CHU de Dijon), menée au Canada par le Dr Jim Biagi (Kingston General Hospital, Kingston) a été financée en France par le Ministère de la Santé et par la Ligue nationale contre le cancer.
L’étude clinique franco-canadienne PRODIGE 24/CCTG PA.6 conduite par Unicancer et le Groupe canadien des essais sur le cancer (CCTG) auprès de 500 patients opérés d’un adénocarcinome canalaire du pancréas (forme la plus fréquente de cancer du pancréas) montre une augmentation significative de la survie chez les patients traités par le protocole de chimiothérapie mFOLFIRINOX en comparaison du traitement standard par gemcitabine. Cette étude internationale coordonnée par le Pr Thierry Conroy (Institut de cancérologie de Lorraine, Nancy), ainsi que le Pr Jean-Baptiste Bachet (Hôpital La Pitié-Salpêtrière, AP-HP, Paris) et le Pr Patrick Rat (CHU de Dijon), menée au Canada par le Dr Jim Biagi (Kingston General Hospital, Kingston) a été financée en France par le Ministère de la Santé et par la Ligue nationale contre le cancer.
Ces travaux, qui constituent une avancée significative pour le traitement de ces patients, sont publiés le 20 décembre 2018 dans la prestigieuse revue The New England Journal of Medicine.
L’incidence des cancers du pancréas augmente régulièrement depuis plusieurs années. Après chirurgie curative, une chimiothérapie « de précaution » (dite adjuvante), visant à réduire le risque de récidive, et utilisant la gemcitabine pour une durée de 6 mois, était le standard thérapeutique depuis plus de 10 ans.
Réduction de moitié du nombre de patients présentant une récidive
D’avril 2012 à octobre 2016, 493 patients ont été inclus dans l’étude PRODIGE 24 par 77 établissements hospitaliers, grâce à la collaboration de trois groupes de recherche français réunis sous l’égide de l’Intergroupe PRODIGE : Unicancer Gastrointestinal (UCGI), la Fédération Francophone de Cancérologie Digestive (FFCD) et le Groupe Coopérateur Multidisciplinaire en Oncologie (GERCOR), et un groupe de recherche canadien, le Canadian Cancer Trials Group (CCTG).
L’étude montre une réduction de moitié du nombre de patients présentant une récidive de leur maladie 3 ans après la chirurgie : deux patients sur cinq sans récidive chez ceux traités par mFOLFIRINOX versus un sur cinq chez ceux traités par gemcitabine. De la même façon, la survie à 3 ans des patients est considérablement améliorée : environ deux patients sur trois vivants versus un sur deux, respectivement dans chaque bras de traitement.
Les effets indésirables sévères sont plus importants avec le mFOLFIRINOX, notamment des diarrhées (19 % versus 4 %) et fourmillements dans les mains et les pieds (9 % versus 0 %) ; ils sont cependant bien pris en charge par les équipes médicales. Ces toxicités nécessitent une réduction de dose chez certains patients, ce qui n’entraîne pas de perte de bénéfice clinique.
Le mFOLFIRINOX s’impose aujourd’hui comme le nouveau standard thérapeutique de chimiothérapie adjuvante chez les patients opérés d’un adénocarcinome du pancréas et présentant un bon état général. Les résultats publiés dans le New England Journal of Medicine ont fait l’objet d’une communication préalable au congrès de l’American Society of Clinical Oncology (ASCO) en juin 2018.
À propos du cancer du pancréas
L’agence Santé publique France (anciennement Institut de Veille Sanitaire) a estimé en 2017 à environ 14 200 le nombre de nouveaux cas annuels de cancer du pancréas en France. Parmi les cancers du pancréas exocrine, l’adénocarcinome canalaire pancréatique représente 90 à 95 % des formes de ce cancer. La grande majorité des personnes diagnostiquées a plus de 60 ans. Le diagnostic est le plus souvent réalisé à un stade avancé du fait d’une expression clinique tardive de la maladie. Seuls 15% à 20% des patients sont diagnostiqués à un stade où la tumeur est résécable et, lorsqu’elle est possible, la chirurgie est le traitement principal du cancer du pancréas.
Tous stades confondus, la survie à 5 ans est en France de 6 à 7% (données 1989-2010). Chez ces patients opérés, la chimiothérapie adjuvante par gemcitabine prolonge la survie par rapport à la chirurgie seule et augmente de manière significative la proportion de patients chez lesquels le cancer n’est pas réapparu.
A propos du New England Journal of Medicine
The New England Journal of Medicine est la revue médicale générale et le site Web le plus lu, le plus cité et le plus influent au monde, et le plus ancien périodique médical, publié depuis 1812. C’est une revue dédiée aux innovations majeures, largement reconnue comme le gold standard de la recherche actuelle et des meilleures pratiques médicales. Selon le Journal Citation Reports, son facteur d’impact était de 79.258 en 2017, ce qui la place comme la revue dont les articles sont les plus cités dans la littérature médicale.
Source
FOLFIRINOX versus Gemcitabine as Adjuvant Therapy for Pancreatic Cancer
Authors: Thierry Conroy, M.D., Pascal Hammel, M.D., Ph.D., Mohamed Hebbar, M.D., Ph.D., Meher Ben Abdelghani, M.D., Alice C. Wei, M.D., C.M., M.Sc., F.R.C.S.C., F.A.C.S., Jean-Luc Raoul, M.D., Ph.D., Laurence Choné, M.D., Eric Francois, M.D., Pascal Artru, M.D., James Joseph Biagi, M.D., F.R.C.P.C., Thierry Lecomte, M.D., Ph.D., Eric Assenat, M.D., Ph.D., Roger Faroux, M.D., Marc Ychou, M.D., Ph.D., Julien Volet, M.D., Alain Sauvanet, M.D., Gilles Breysacher, M.D., Frédéric Di Fiore, M.D., Ph.D., Christine Cripps, M.D., F.R.C.P.C., Petr Kavan, M.D., Ph.D., Patrick Texereau, M.D., Karine Bouhier Leporrier, M.D., Faiza Khemissa-Akouz, M.D., Jean-Louis Legoux, M.D., Béata Juzyna, Eng, Sophie Gourgou, M.Sc., Christopher J. O’Callaghan, D.V.M., Ph.D., Claire Jouffroy-Zeller, Pharm.D, Patrick Rat, M.D., David Malka, M.D., Ph.D., Florence Castan, M.Sc., Jean-Baptiste Bachet, M.D., Ph.D., for the Canadian Cancer Trials Group and the UNICANCER-GI /PRODIGE Group
Affiliations: From Institut de Cancérologie de Lorraine and Université de Lorraine, Nancy, France (T.C.); Hôpital Beaujon, Clichy, France and Université Paris VII (P.H., A.S.); Hôpital Huriez, Lille, France (M.H.); Centre Paul Strauss, Strasbourg, France (M.B.A.); Princess Margaret Cancer Centre, Toronto, Canada (A.C.W.); Institut Paoli-Calmettes, Marseille, France (J-L.R.); Centre Hospitalier Universitaire, Nancy, France (L.C.); Centre Antoine-Lacassagne, Nice, France (E.F.); Hôpital Jean-Mermoz, Lyon, France (P.A.); Kingston General Hospital, Kingston, Canada (J.J.B.); Hôpital Trousseau, Tours, France (T.L.); Centre Hospitalier Universitaire de Saint-Eloi, Montpellier, France (E.A.); Centre Hospitalier Départemental Vendée, La Roche-sur-Yon, France (R.F.); Institut du Cancer Montpellier – Val d’Aurelle, Université de Montpellier, Montpellier, France (M.Y., S.G., F.C.); Centre Hospitalier Universitaire Robert Debré, Reims, France (J.V.); Hôpital Louis Pasteur, Colmar, France (G.B.); Normandie University, Rouen University Hospital, Digestive Oncology Unit, Rouen, France (F.D.F.); Ottawa Health Research Institute, Canada (C.C.); Segal Cancer Center, Jewish General Hospital, Montréal, Canada (P.K.); Hôpital Layné, Mont-de-Marsan, France (P.T.); Centre Hospitalier Universitaire Côte de Nacre, Caen, France, (K.B-L.); Hôpital Saint-Jean, Perpignan, France (F.K-A.); Centre Hospitalier Régional, Orléans, France (J-L.L.); R&D Unicancer, Paris, France (B.J., C.J-Z.); Canadian Cancer Trials Group, Queen’s University, Canada (C.J.O.); Gustave Roussy, Université Paris-Saclay, Villejuif, France (D.M.); Centre Hospitalier Universitaire, Dijon, France (P.R.); Sorbonne Université, Hôpitaux Universitaires Pitié-Salpétrière, APHP, Paris, France (J-B.B).



